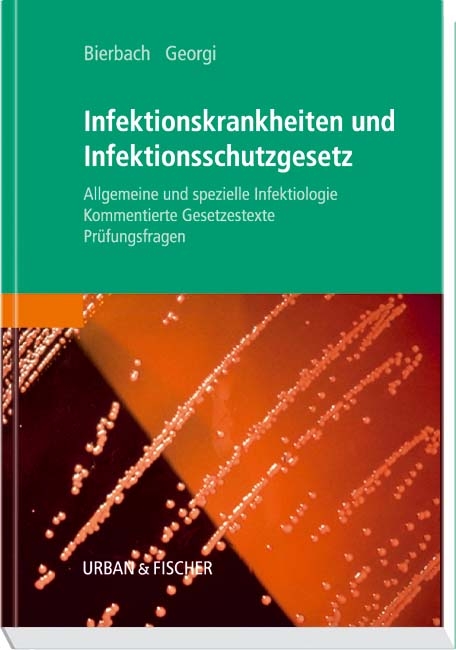
Infektionskrankheiten und Infektionsschutzgesetz - Peter Georgi, Elvira Bierbach

Infektionskrankheiten und Infektionsschutzgesetz
Allgemeine und spezielle Infektiologie, kommentierte Gesetzestexte, Prüfungsfragen
Seiten
2003
|
1., Aufl.
Urban & Fischer in Elsevier (Verlag)
978-3-437-56770-4 (ISBN)
Urban & Fischer in Elsevier (Verlag)
978-3-437-56770-4 (ISBN)
- Titel ist leider vergriffen;
keine Neuauflage - Artikel merken
Infektionskrankheiten sind ein Prüfungsschwerpunkt der Amtsarztprüfung, gilt es doch zu überprüfen, welche Krankheiten der Heilpraktiker nicht behandeln darf. Hier finden Sie das ausführlich abgefragte Prüfungsthema sorgfältig aufbereitet:
Grundlagen der Infektiologie und Epidemiologie: Allgemeine Infektionslehre, Pathogenität und Virulenz, Prinzipien der immunologischen Infektabwehr
Infektionskrankheiten: alphabetisch geordnet
Infektionsschutzgesetz: Inhalte und Ziele der gesetzlichen Bestimmungen
Lernhilfen, Prüfungsfragen und Übersichten.
Grundlagen der Infektiologie und Epidemiologie: Allgemeine Infektionslehre, Pathogenität und Virulenz, Prinzipien der immunologischen Infektabwehr
Infektionskrankheiten: alphabetisch geordnet
Infektionsschutzgesetz: Inhalte und Ziele der gesetzlichen Bestimmungen
Lernhilfen, Prüfungsfragen und Übersichten.
Elvira Bierbach. Herausgeberin und Mitautorin von "Naturheilpraxis heute", Autorin von "Das Infektionsschutzgesetz". Leiterin einer Heilpraktikerschule. Dr. Peter Georgi: Autor von "Infektionskrankheiten für Heilpraktiker" (ehemaliger Aescura-Titel).
| Sprache | deutsch |
|---|---|
| Maße | 170 x 240 mm |
| Gewicht | 735 g |
| Einbandart | Pappe |
| Themenwelt | Medizin / Pharmazie ► Naturheilkunde ► Heilpraktiker-Ausbildung |
| Schlagworte | HC/Medizin/Ganzheitsmedizin • Heilpraktikerausbildung • Heilpraktiker; Prüfungsvorbereit. • Infektion / Infektionskrankheiten |
| ISBN-10 | 3-437-56770-5 / 3437567705 |
| ISBN-13 | 978-3-437-56770-4 / 9783437567704 |
| Zustand | Neuware |
| Informationen gemäß Produktsicherheitsverordnung (GPSR) | |
| Haben Sie eine Frage zum Produkt? |
Mehr entdecken
aus dem Bereich
aus dem Bereich
Buch | Softcover (2023)
Urban & Fischer (Verlag)
CHF 58,75
Lehrbuch und Atlas
Buch | Hardcover (2024)
Urban & Fischer in Elsevier (Verlag)
CHF 128,00


